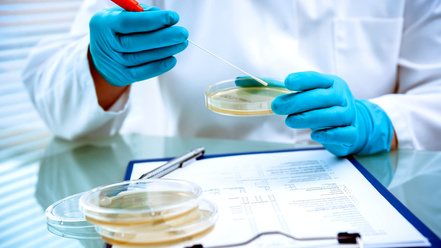

Nach den Salmonellen-Infektionen in zwei Seniorenheimen im Kreis Emmendingen sind die polizeilichen Ermittlungen abgeschlossen. Eine Ursache für die Infektionen wurde nicht gefunden, sagte uns die Staatsanwaltschaft Freiburg. Ende Juli waren rund dreißig Bewohner der Altenpflegeheime in Endingen und Rheinhausen an Brechdurchfall erkrankt. Zwei Menschen starben. Beide waren aber vorerkrankt, es gibt keine Hinweise, dass ihr Tod mit den Salmonellen-Infektionen zusammenhängt, so die Staatsanwaltschaft. Salmonellen sind in Deutschland meldepflichtig - die lösen bei den Infizierten meist starke Magen-Darm-Probleme aus. Durch den damit verbundenen Flüssigkeitsverlust kann die Erkrankung bei alten und immunschwachen Menschen sogar lebensbedrohlich verlaufen.